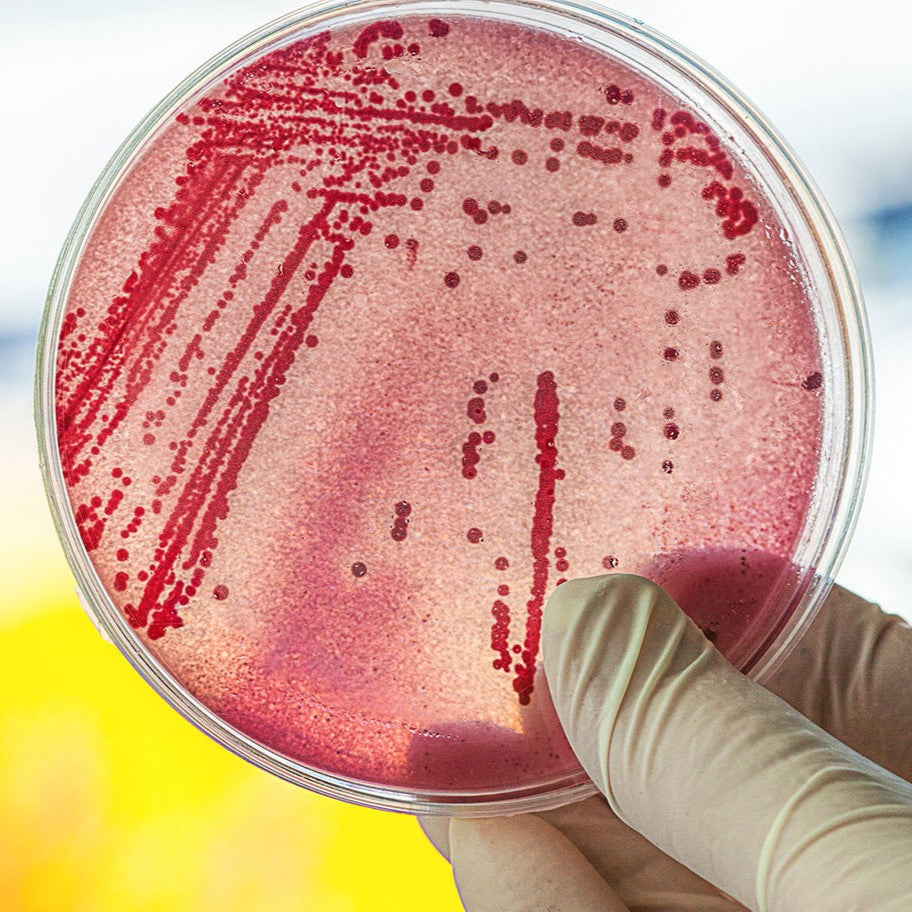

Escherichia coli (E. coli) son bacterias que pueden habitar en los intestinos de humanos y animales. Aunque la mayoría de las cepas de E. coli son inofensivas e incluso beneficiosas para la digestión, algunas cepas patógenas pueden causar enfermedades graves. Entre ellas, la E. coli O157 es particularmente conocida por provocar infecciones alimentarias severas. Estas infecciones pueden causar síntomas que van desde diarrea leve hasta afecciones potencialmente mortales, como el síndrome urémico hemolítico (SUH), que puede conducir a insuficiencia renal. Protegerte a ti y a tu familia de la E. coli es esencial debido a estos posibles riesgos para la salud.
Comprendiendo la E. coli
¿Qué es la E. coli? E. coli es un grupo diverso de bacterias. La mayoría son no patógenas y coexisten de forma inofensiva en los intestinos. Sin embargo, las cepas patógenas, como la E. coli O157, pueden producir toxinas que causan enfermedades. Según los Centros para el Control y la Prevención de Enfermedades (CDC), estas cepas dañinas pueden provocar síntomas gastrointestinales graves y, en algunos casos, complicaciones más serias.
Síntomas e implicaciones para la salud
Las infecciones por E. coli suelen manifestarse como cólicos estomacales, diarrea (que puede ser sanguinolenta), náuseas y vómitos. En poblaciones vulnerables, como niños pequeños, ancianos y personas con sistemas inmunitarios debilitados, las infecciones por E. coli pueden ser más graves y potencialmente mortales. Complicaciones como el SUH pueden causar insuficiencia renal y problemas de salud a largo plazo.
Fuentes de contaminación por E. coli
- Contaminación alimentaria
E. coli puede contaminar los alimentos a través de diversos caminos. Una manipulación inadecuada, la cocción insuficiente y la contaminación cruzada son riesgos significativos. Por ejemplo, la E. coli puede transferirse de la carne cruda a otros alimentos mediante utensilios o superficies sin lavar. Según el Servicio de Inspección y Seguridad Alimentaria (FSIS), asegurar que la carne se cocine a temperaturas adecuadas es fundamental para eliminar las bacterias dañinas.
- Contaminación ambiental
La E. coli también puede ingresar a los alimentos a través de fuentes ambientales. El agua contaminada utilizada para el riego o el lavado puede propagar la E. coli a frutas y verduras. Además, las prácticas insalubres de manipulación de alimentos y las superficies contaminadas aumentan el riesgo de contaminación. Investigaciones de la Organización Mundial de la Salud (OMS) destacan la importancia del agua limpia y la sanidad en la prevención de enfermedades transmitidas por alimentos.
Estrategias de prevención
Manipulación segura de los alimentos
- Cocción adecuada: Cocinar la carne a la temperatura interna correcta es crucial. Para la carne molida, esto significa alcanzar al menos 71 °C (160 °F), mientras que el pollo debe cocinarse a 74 °C (165 °F). Esta práctica garantiza la eliminación de bacterias dañinas.
- Evitar la contaminación cruzada: Utiliza tablas de cortar y utensilios separados para carnes crudas y otros alimentos. Lávate siempre las manos con agua y jabón antes de manipular alimentos y después de tocar carne cruda.
Lavado de alimentos
- Técnicas de lavado efectivas: Enjuaga frutas y verduras bajo agua corriente para eliminar contaminantes superficiales. Para productos con superficies rugosas, como las papas, utiliza un cepillo. Ten en cuenta que aunque el lavado reduce las bacterias superficiales, puede no eliminar todos los patógenos.
Higiene en la cocina
- Prácticas de desinfección: Limpia y desinfecta regularmente las superficies de la cocina, incluidas encimeras y tablas de cortar, para minimizar el riesgo de propagación de E. coli. Usa agua caliente con jabón y considera un desinfectante para una limpieza completa.
El papel del Milerd Detoxer en la prevención de la contaminación por E. coli
El Milerd Detoxer es un dispositivo avanzado de seguridad alimentaria diseñado para mejorar los procesos de limpieza. Utiliza tecnologías ultrasónicas y oxidativas para eliminar contaminantes de los alimentos. Este dispositivo cuenta con una pantalla LCD a color de 2,4 pulgadas, una pantalla táctil capacitiva y una impresionante eficiencia: 97,6 % para pesticidas, 99,9 % para metales pesados y 96,3 % para mohos.
Eficacia contra la E. coli
La tecnología del Milerd Detoxer proporciona un mecanismo de limpieza exhaustivo que elimina la E. coli y otras bacterias dañinas. Investigaciones de laboratorios suizos y europeos confirman su alta efectividad en la reducción de la contaminación bacteriana, incluida la E. coli, proporcionando así una capa adicional de protección.
Comparación con métodos tradicionales
Los métodos tradicionales de lavado de alimentos, como enjuagar con agua o usar vinagre, a menudo no logran eliminar completamente las bacterias de las superficies y estructuras internas de los alimentos. La limpieza de doble acción del Milerd Detoxer —que combina ondas ultrasónicas con agentes oxidativos— ofrece un rendimiento superior en la eliminación de E. coli y otros contaminantes.
Beneficios para el consumidor al usar Milerd Detoxer
Mayor seguridad alimentaria
El Milerd Detoxer mejora significativamente la seguridad alimentaria al ofrecer un alto nivel de protección contra E. coli y otras sustancias nocivas. Su tecnología avanzada ayuda a garantizar que los alimentos sean más seguros para el consumo, especialmente para familias con niños pequeños o personas con sistemas inmunitarios debilitados.
Preservación de nutrientes
El Detoxer preserva el valor nutricional de los alimentos, lo cual es fundamental para mantener una dieta saludable. A diferencia de algunos métodos tradicionales, no compromete el contenido nutricional mientras mejora la seguridad.
Comodidad y facilidad de uso
El esterilizador de alimentos por ozono es fácil de usar y portátil, lo que lo convierte en una opción práctica tanto para el hogar como para los viajes. Su batería recargable permite hasta 20 ciclos de procesamiento con una sola carga, lo que aumenta su conveniencia.
¡Protege a tu familia de las infecciones por E. coli hoy mismo!
Proteger a tus seres queridos de bacterias dañinas como la E. coli es esencial para su salud y bienestar. Aplica prácticas seguras de manipulación de alimentos, asegúrate de alcanzar las temperaturas de cocción adecuadas y prioriza la limpieza en tu cocina. Da un paso más invirtiendo en el Milerd Detoxer, un dispositivo avanzado diseñado para eliminar eficazmente contaminantes dañinos de los alimentos. Con sus potentes tecnologías ultrasónicas y oxidativas, disfrutarás de la tranquilidad de saber que tus comidas son seguras y nutritivas. Toma la decisión por una mejor seguridad alimentaria hoy: elige el Milerd Detoxer y protege a tu familia de las enfermedades transmitidas por alimentos.

Dejar un comentario
Este sitio está protegido por hCaptcha y se aplican la Política de privacidad de hCaptcha y los Términos del servicio.